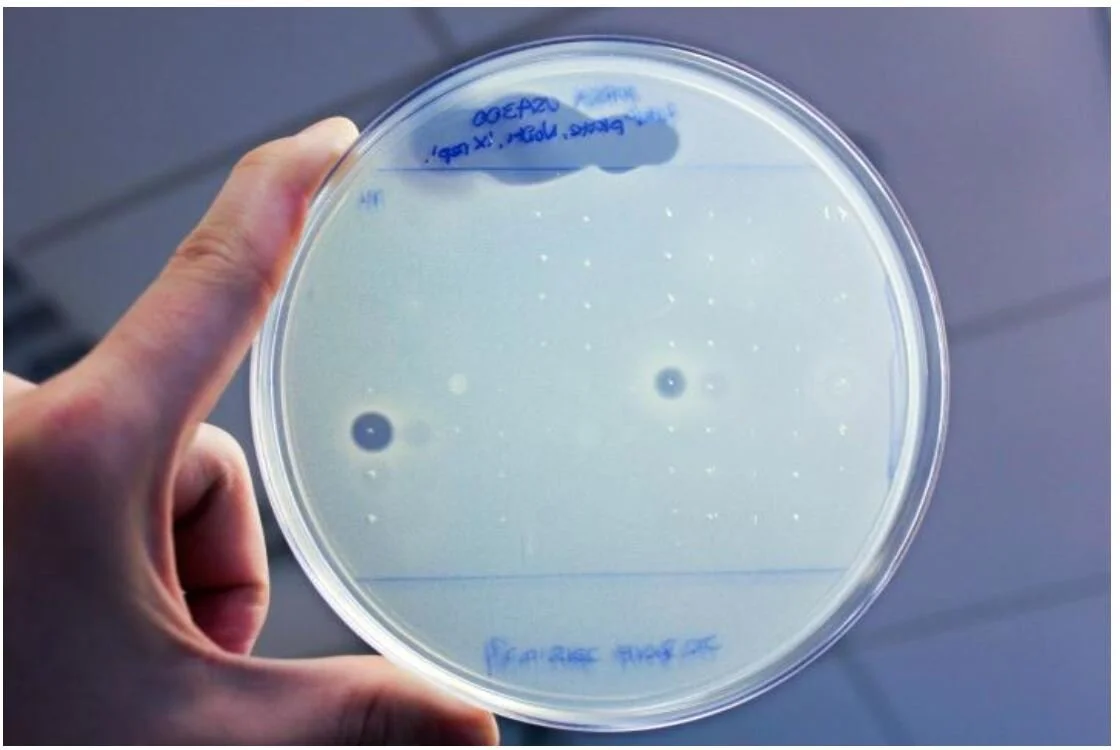
Bacteria Mix Can Boost or Bust Antibiotic Resistance

Conlon Lab Research in the News
Researchers in the UNC School of Medicine’s Department of Microbiology and Immunology and the UNC-NC State Joint Department of Biomedical Engineering have developed a new strategy to improve drug-delivery into chronic wounds infections.
Research from the lab of Brian Conlon, PhD, shows that as the innate immune system attacks Staphylococcus aureus, the immune system also stops antibiotics from being able to efficiently kill. This antagonism may lead antibiotics to fail.
In this issue of Cell Chemical Biology, Radlinski et al. (2019) identify Pseudomonas-derived rhamnolipids that potentiate aminoglycoside antibiotics in the eradication of antibiotic-tolerant bacterial phenotypes. Microbial physiological and mechanistic studies indicate that rhamnolipids permeabilize S. aureus membrane and drive the uptake of aminoglycosides that is independent of proton-motive force.
Staphylococcus aureus bacteria are a major cause of serious infections that often persist despite antibiotic treatment, but scientists have now discovered a way to make these bacteria much more susceptible to some common antibiotics.
Understanding the precise mix of bacteria and their interactions could become a standard part of clinical practice in treating bacterial infections.
Led by UNC School of Medicine's Brian Conlon, PhD, research published in PLoS Biology shows how different bacterial strains interact to make each other more or less resistant to antibiotics.
Hospital-related staph infections are rampant. In 2005 alone there were an estimated 478,000 cases in the U.S., according to the Centers for Disease Control and Prevention. The numbers are dropping, the agency recently reported in a release, "but more work is needed."